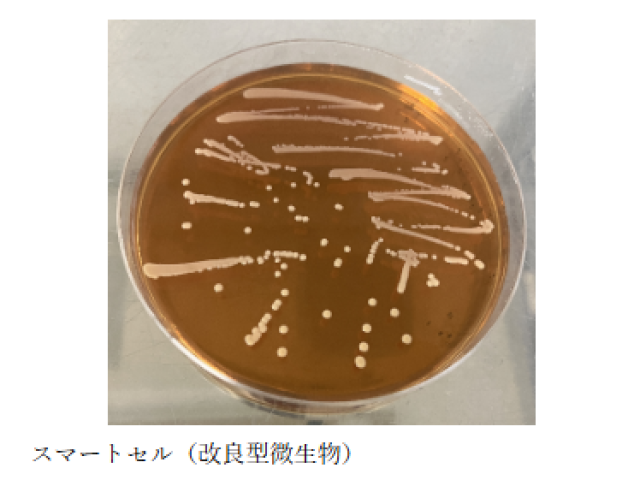

つくばと世界のイノベーションをつなぐ場
つくばと世界のイノベーションをつなぐ場

石油に頼らないバイオものづくりの実現を目指しています。
Fermentation based chemical production
BioPhenolicsは石油化学産業からバイオものづくり産業への転換を目指しています。当社の技術はバイオマス(植物)を原料として改良型微生物を用いた発酵法によりバイオ化学品を生産する技術です。バイオ化学品は大気中の二酸化炭素を固定化したものであり、脱炭素製品の原料になるため、「石油を原料に使わない」「バイオマスを使う循環型資源」「大気中の二酸化炭素低減」を同時に実現することが出来ます。
当社の強みはラボ(研究)~ベンチ工場(プロセス・量産化開発)まで統合された研究開発環境を保有し、真に経済性のあるバイオ化学品の生産技術開発を行っている点です。また、当社は硬いプラスチックの原料となる芳香族化学品を中心としたバイオ化学品事業、バイオものづくりに関するプロセス/量産開発の受託開発事業およびコンサルティング事業を行っております。
解決したい課題
石油に頼らずにプラスチック原料となる化学品を生産する。
そのためにバイオマスを原料にして、改良型微生物を用いた発酵法によりバイオ化学品の生産技術開発を行っています。
1.芳香族バイオ化学品の研究リソース
2.ベンチスケール(90L発酵槽)までの発酵及び精製プロセス開発および受託培養
3.バイオものづくりコンサルティング

本社・代表取締役
貫井憲之
筑波大発スタートアップです。
バイオの力でカーボンニュートラルや循環型社会の実現に貢献します。
| 会社名 Company Name |
BioPhenolics株式会社 (バイオフェノリクス) |
|---|---|
| 住所 Address |
〒305-2635 |
| URL | https://www.bio-phenolics.com/ |
| 代表者 President |
貫井憲之 |
|---|---|
| 設立年 Established |
西暦 2023年 4月 |
| 資本金 Capital |
55,000千円 |
| 上場区分 Listed or not |
未上場 |
| 株主 Shareholders |
貫井憲之、高谷直樹、ANRI、JST SUCCESS |
| 主要取引先 Major clients |
大手化学メーカー |
| 従業員数 Employees |
6 |